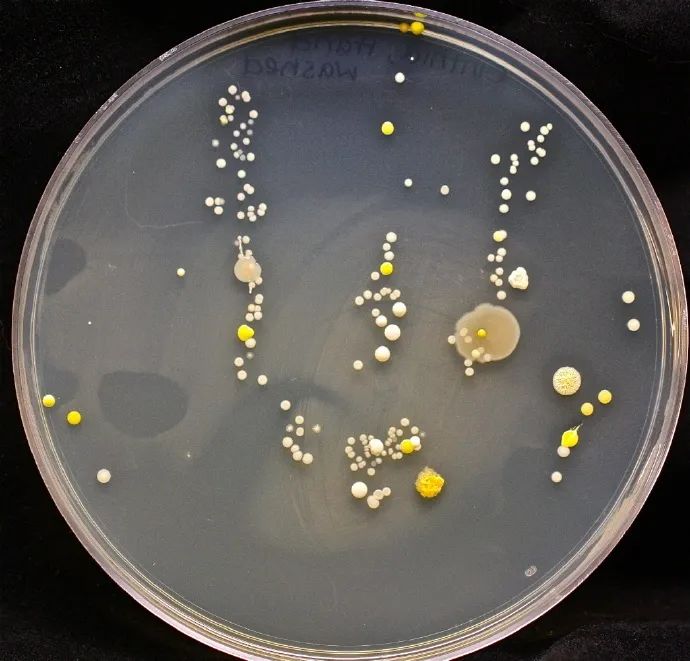
小朋友看完这篇硬核科普你要还是坚持不洗手算你狠

微球菌属

微球菌属
图片尺寸1280x960
藤黄微球菌
图片尺寸472x317
球菌图片_球菌图片大全_球菌图片素材
图片尺寸595x350
微球菌
图片尺寸720x960
单球菌
图片尺寸220x306
表皮葡萄球菌(医学微生物学 名词)
图片尺寸1200x1032
微生物实验考试 葡萄球菌
图片尺寸1080x810
微球菌
图片尺寸720x1280
图 4 规则微球
图片尺寸700x509
【staphylococcus aureus金黄色葡萄球菌.
图片尺寸800x640
革兰氏染色阳性,球菌
图片尺寸362x350
球菌图片_全景网
图片尺寸670x578葡萄球菌,球形细菌
图片尺寸1200x891
玫瑰色微球菌
图片尺寸1280x1147
球菌
图片尺寸610x561
显微镜下染色后的葡萄球菌金黄色葡萄球菌 在琼脂培养基上的菌落显现
图片尺寸1080x829
藤黄微球菌图片
图片尺寸400x300
球菌
图片尺寸500x400
小朋友看完这篇硬核科普你要还是坚持不洗手算你狠
图片尺寸690x661
常见细菌对人的致病性. 光学显微镜油镜 扫描电子显微镜 葡萄球菌
图片尺寸1080x810